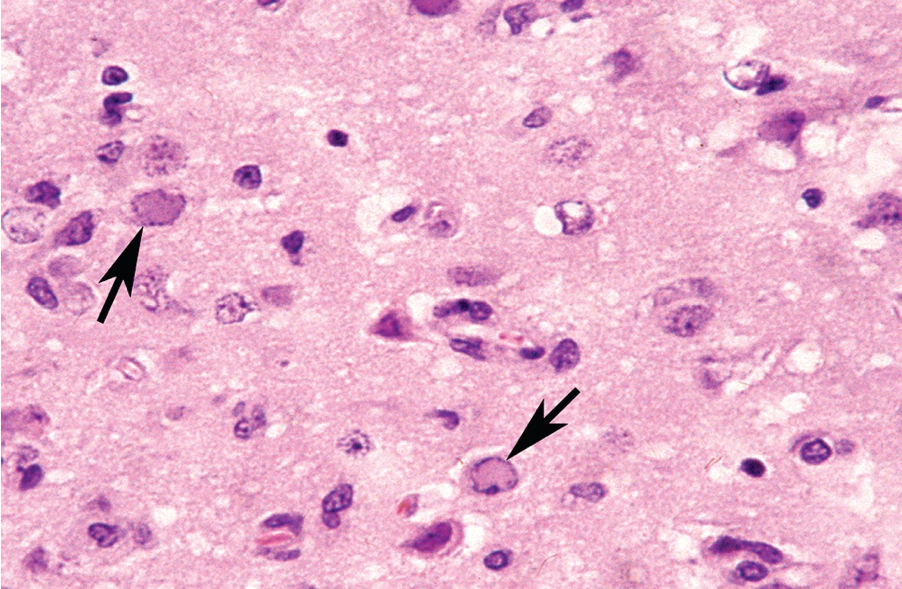

Name the labeled structures

Alimentary tract from a mature rabbit, illustrating the
prominent gut-associated lymphoid tissue (GALT), including a Peyer’s
patch (A) in the wall of the ileum, the sacculus rotundus (B) at the
terminal ileum, the cecal tonsil (C) in wall of the proximal cecum, and
the cecal appendix (D) at the terminus of the cecum.
Name the tissue type and common cell type present.

GALT from a normal mature rabbit, depicting the
common presence of histiocytes filled with refractile particulate debris
within the follicular center.
Name the structure

Pulmonary artery of a normal rabbit. Pulmonary arteries
are highly muscular, which can be misinterpreted as muscular
hypertrophy.
Describe the structure and its incidence

Female reproductive tract of a normal doe, depicting the 2
separate cervices, which is typical for this species. The uterus is
bicornuate, with 2 separate horns.
Name the tissue, describe the lesion, name the cause

Integument from a rabbit with leporid herpesvirus 4
infection, depicting necrosis of the epidermis and papillary dermis with
underlying dermal hemorrhage.
describe the notable structures (arrows)

Leporid herpesvirus 4 infection of the skin from a rabbit, depicting a multinucleate syncytium and intranuclear inclusion bodies (arrows) in the follicular epithelium.
Cerebrum. Name the structures and causative agent.
Cerebrum from a rabbit with naturally acquired herpes
simplex virus encephalitis. Note the prominent intranuclear inclusion
bodies in neurons (arrows) and astroglia
1) Causative agent, genus
2) Usual means of transmission
3) Potential sequalae in NZW

1) Cottontail rabbit papillomavirus, Kappapapillomavirus
2) Insect vectors, e.g. mosquitos and ticks
3) squamous cell carcinoma
Describe. What is the most likely cause?

Solitary papilloma on the ear of a laboratory rabbit naturally infected with cottontail rabbit papilloma virus (CRPV).
1) causative agent
2) means of transmission
3) potential sequale
4) describe histology

1) rabbit oral papillomavirus
2) direct contact, including does to kits
3) none - no reports of malignant transformation
4) basophilic intranuclear inclusions and viral antigen in the stratun spinosum
1) tissue
2) arrow
3) cause
4) associated disease

1) Describe the lesions
2) causative agent

1) Mucopurulent conjunctivitis, periocular swelling, and
facial edema (myxomatosis)
2) myxoma virus
3) family Poxviridae, genus Leporipoxvirus
Tissue, arrows, cause

Intracytoplasmic inclusion bodies (arrows) in the
conjunctival epithelium of a rabbit with myxomatosis.
tissue, pathology, cause

Lymph node, depicting hypertrophy and hyperplasia of stellate myxoma cells and severe lymphocytic depletion.
Rabbit respiratory epithelium with intracytoplasmic inclusions (arrows). name the cause

Myxoma virus
Cause
related to

Rabbit (Shope) fibroma
myxoma virus
describe
arrows
cause

Skin of a Sylvilagus rabbit infected with Shope fibroma
virus. There is a dense network of fusiform to polyhedral fibroblasts in
the dermis, many of which contain prominent intracytoplasmic
inclusion bodies (arrows).
Organ, gross description, cause

Lungs from a wild Oryctolagus rabbit with acute rabbit
hemorrhagic disease (RHD) virus infection. There is marked pulmonary
edema with multifocal ecchymoses.
tissue, microscopic description, cause

Lung from a case of RHD in a feral Oryctolagus rabbit from Australia. Notemultiple intravascular thromboses
organ, gross description, cause

Liver from a domestic rabbit naturally infected with
RHD virus. Note the granular texture of the hepatic capsule and
accentuated lobular pattern.
tissue, microscopic description, cause

Liver from a rabbit experimentally infected with rabbit
hemorrhagic disease virus. Note the acute periportal and midzonal
hepatocellular necrosis.
tissue, microscopic description, cause

Small intestine from a juvenile rabbit with a natural case
of epizootic rotaviral enteritis. There is submucosal edema, with
blunting and fusion of villi. Enterocytes within crypts and on villi are
immature, indicative of regeneration.
tissue, microscopic description

Acute fibrinopurulent bronchopneumonia in a young
rabbit infected with Bordetella bronchiseptica. The terminal airway
and alveoli are flooded with fibrin-rich exudate.
Tissue
agent
distribution
stain

Lung of a rabbit naturally infected with cilia-associated
respiratory (CAR) bacillus. This organism colonizes the epithelium of
the larynx, trachea, and bronchi in the rabbit. Note the prominent
peribronchiolar lymphocytic infiltration (Warthin-Starry stain).